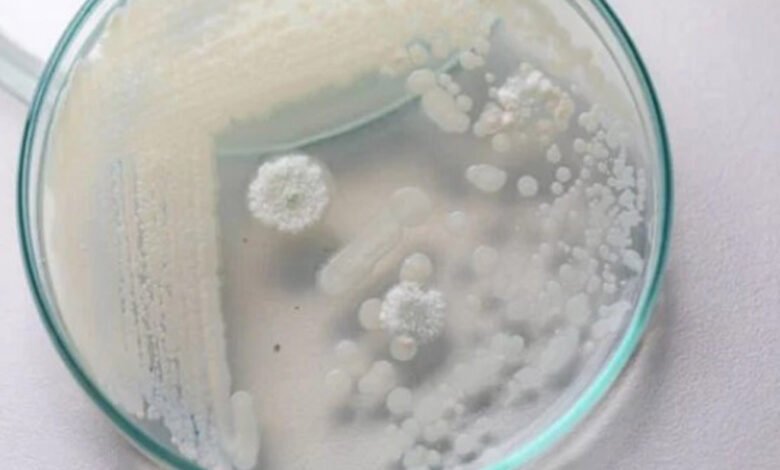

Estilo : TV & Fama
Celebridades
Quem era o ator Jeff Machado, encontrado morto no Rio de Janeiro
▻Metropoles
Estilo : TV & Fama
Celebridades
Corpo de Jeff Machado foi encontrado com sinais de estrangulamento, diz advogado
▻Metropoles
Estilo : Saúde
Curiosidade
Homem faz transfusão com sangue do filho de 17 anos para rejuvenescer
▻Metropoles
Estilo : Saúde